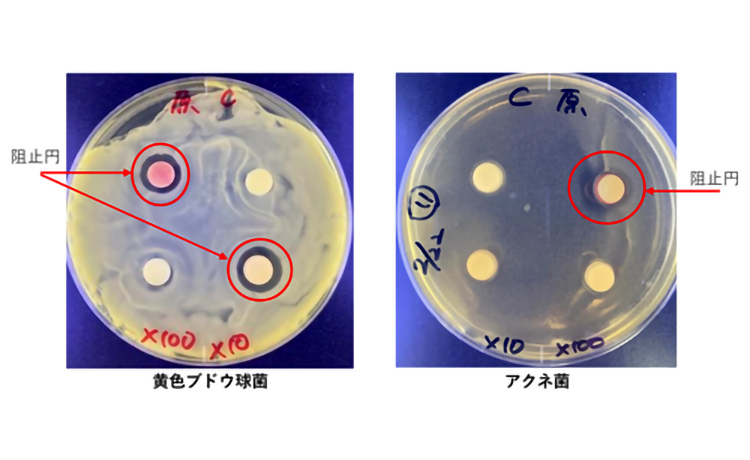

原料紹介
薬用植物の販売原料紹介
「シコンエキス」(販売原料名:油溶性シコンエキス Cen)
絶滅危惧種のムラサキの根「紫根(シコン)」
長年の研究により、国内での栽培技術を確立
当社では2006年より「紫根」の国内栽培に取り組み、ムラサキの生存率を高め、有効成分の含有量を増加させることができる独自の「ムラサキの栽培方法」※1を開発し、安定生産を可能にする栽培技術の確立に成功しました。さらに、「紫根」から抽出した「シコンエキス」の肌への効果を研究した結果、コラーゲン産生のサポートや育毛効果などが期待できることを確認しています。
※1 登録番号:特許第5885320号、登録日:2016年2月19日、発明の名称:ムラサキの栽培方法
コラーゲン産生をサポートする効果
「シコンエキス」には、低濃度でもコラーゲンを産生する線維芽細胞を増殖させる高い効果があることを確認しており、肌のハリや弾力を保つことが期待されます。
<試験内容>
正常ヒト皮膚由来線維芽細胞(NB1RGB)を播種後、翌日に各評価サンプル(紫根に含まれる主要成分:シコニン類(シコニンおよびアセチルシコニン))を含む培地に交換。さらに3日後、Hoechst試薬により細胞のDNAを蛍光染色し、蛍光顕微鏡による観察および蛍光強度(Ex=355nm、Em=460nm)を測定。その結果、シコニン類は0.01~0.1μMの低濃度において線維芽細胞を増殖する効果を確認しました。
育毛効果
「シコンエキス」には、発毛や育毛をサポートする毛乳頭細胞を増殖させる効果があることを確認しており、育毛の促進や毛髪を太く育む効果が期待されます。
<試験内容>
ヒト由来毛乳頭細胞を培地に播種した翌日に、各評価サンプルを含む培地に交換。さらに2日後、細胞のDNAを蛍光染色し、蛍光顕微鏡による観察および蛍光強度(Ex=355nm、Em=460nm)を測定。その結果、シコンエキスの有効成分であるシコニンを含む毛乳頭細胞は、評価サンプルを含まない培地を100とした場合、約10%増殖することを確認しました。さらに、ビタミンCと比較しても、シコニンを含む毛乳頭細胞の増殖効果がより高いことを確認しました。
抗菌効果
「シコンエキス」には、肌の悪玉菌とされる黄色ブドウ球菌やアクネ菌に対する抗菌効果があることを確認しており、ニキビなどの肌トラブルを防ぐことが期待されます。
<試験内容>
黄色ブドウ球菌、アクネ菌を培地上に塗布し、シコンエキスを含むフィルターを置き、菌が生育するまで培養。その結果、シコンエキスを含むフィルター周辺に各菌が生育しないことを示す阻止円※2が形成されていることを確認しました。
※2 フィルター周辺に菌が生育していない円状のエリア
「カンゾウフラボノイド」(販売原料名:カンゾウフラボノイド SG P)
国内栽培が難しい「甘草(カンゾウ)」
研究を重ね、国内での独自栽培方法を確立
当社では2006年より、輸入に頼らず国内で安定的に甘草を確保することをめざして、栽培研究に取り組んできました。その中で、生薬として用いられる根を肥大化させるために独自の「ストロン抑制短筒栽培法」※3を開発し、安定生産を可能にする栽培技術の確立に成功しました。
※3 登録番号:特許第5635714号、登録日:2014年10月24日、発明の名称:カンゾウ属植物の栽培方法
日本初スペインカンゾウの新品種「新日本製薬GG01」※4の開発、品種登録
2008年からは日本薬局方に収載されている「Glycyrrhiza uralensis(ウラルカンゾウ)」と「Glycyrrhiza glabra(スペインカンゾウ)」のうち、生育が旺盛な「スペインカンゾウ」に着目し、品種開発を始めました。スペインカンゾウの種子から100個体を育成・栽培し、根の重量や主要成分グリチルリチン酸含有量に優れる個体を段階的に選抜。その1個体を増産し、2サイクルの栽培・収穫で成分と根の重量の再現性を確認しました。
約14年にわたる研究の結果、植栽から1年半で日本薬局方の主要成分グリチルリチン酸の含有基準値(2.0%)を満たす新品種「新日本製薬GG01」※4を開発し、2022年3月に日本で初めてスペインカンゾウの新品種として登録されました。さらに、この独自品種から抽出した「カンゾウフラボノイド」の肌への効果を研究した結果、シミ予防効果があることを確認しています。
※4 登録番号:29026、農林水産植物の種類:Glycyrrhiza glabra L.、登録品種の名称:新日本製薬GG01
シミ予防効果
「カンゾウフラボノイド」には、メラニンの生成を抑える効果があることを確認しており、シミ予防効果が期待されます。
<試験内容>
B16細胞を播種した翌日に、カンゾウフラボノイドを含む培地を添加。さらに2日後、メラニン量(10%DMSO を含む 1N NaOH で溶解し、吸光度490nmを測定)と Bradford 法にてタンパク質あたりのメラニン量を測定。
その結果、0.0005%まではメラニン量の穏やかな減少傾向を確認しました。
販売概要
販売原料名・容量
- 油溶性シコンエキス Cen: 800g
- カンゾウフラボノイド SG P: 5g (1g×5袋)
※当ページでは、生薬として言及する場合は漢字、植物名・原料名として言及する場合はカタカナで表記しております。
※当ページの内容は薬機法等諸法規に基づくものではありません。